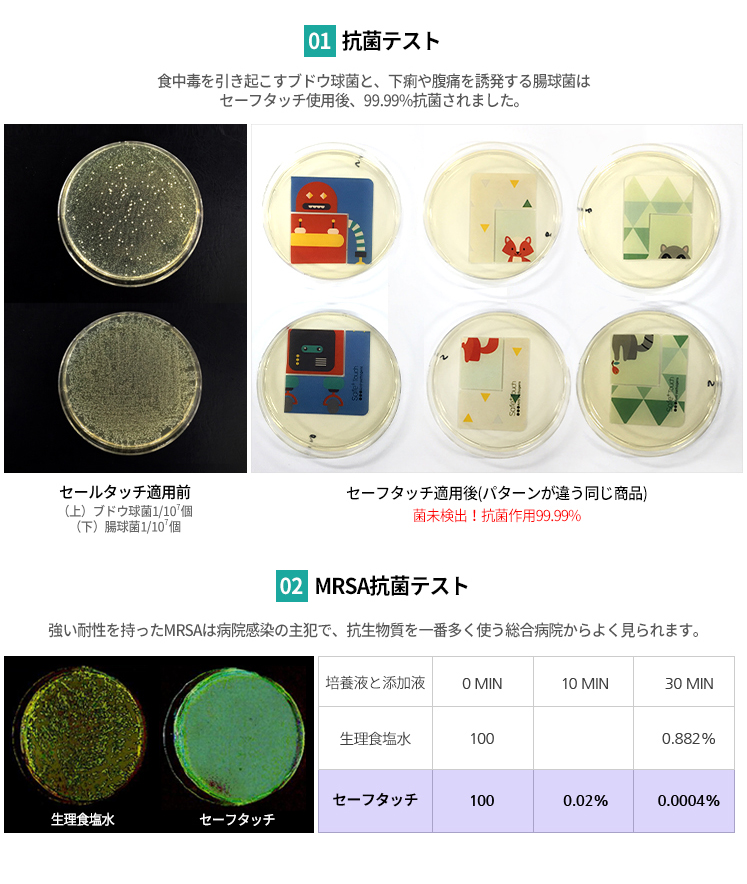

セーフタッチ 抗菌テープ (幅11cm X 長さ5m)








| 商品名 | セーフタッチ 抗菌テープ |
| サイズ | 幅11cm x 長さ5m |
| 原産国 | KOREA |
| タイプ | Anti-pathogenic switch cover |
| 注意事項 |
●強い摩擦を与える場合、抗菌コーティングが剥がれる可能性がありますのでウェットティッシュ又は柔らかいタオルを水に濡らして拭くのをお勧めします。 ●平均的な貼替え時期はお使いの環境によって前後しますが、半年〜1年の目安となります。 |
セーフタッチ 抗菌テープ (幅11cm X 長さ5m)

| 商品名 | セーフタッチ 抗菌テープ |
| サイズ | 幅11cm x 長さ5m |
| 原産国 | KOREA |
| タイプ | Anti-pathogenic switch cover |
| 注意事項 |
●強い摩擦を与える場合、抗菌コーティングが剥がれる可能性がありますのでウェットティッシュ又は柔らかいタオルを水に濡らして拭くのをお勧めします。 ●平均的な貼替え時期はお使いの環境によって前後しますが、半年〜1年の目安となります。 |